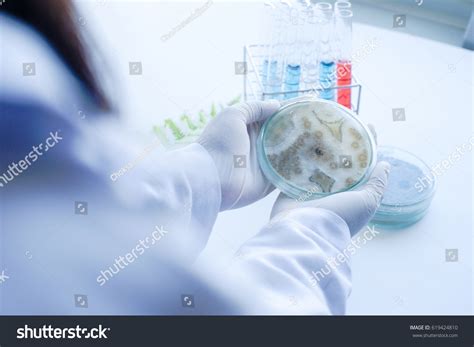
surface contamination testing royalty  images stock

Jika kamu sedang mencari Surface Contamination, maka anda berada di halaman yang tepat. Kami menyediakan aneka Surface Contamination yang bisa anda pesan online. Silakan hubungi kami via +6282245078486, jangan lupa sertakan juka gambar yang diinginkan.
Kami mengirim paket Surface Contamination melalui berbagai ekspedisi, misalnya JNE, JNT, POS, dll. Kami juga menerima pembayaran via BCA/Mandiri/dll. Pengiriman biasanya tidak sampai seminggu sudah sampai dan kami sertakan pula nomor resi yang bisa digunakan untuk tracking barang secara online.

Tidak hanya Surface Contamination, anda juga bisa melihat gambar lain seperti
GI Sheet,
Cable Treeing,
Measurement Equipment,
Monitor Icon,
Optical Isolator,
Musca Domestica,
Test Kit,
Meter,
Aluminum,
Monitor,
Coatings,
Ceramic Film,
Titanium,
Fabric,
Vessel,
Artificial,
Concrete,
Aircraft,
Water,
William Rutula,
and Detector.
Berbagai Contoh Surface Contamination
Berikut kami sertakan berbagai contoh gambar untuk Surface Contamination, silakan save gambar di bawah dengan klik tombol pesan, anda akan kami arahkan pemesanan via WA ke +6282245078486.
 1024×768
1024×768
surface contamination investigations anderson materials evaluation
Order Sekarang
 407×241
407×241
skinsurface contamination services manitoba health safety
Order Sekarang
 1500×1101
1500×1101
surface contamination testing royalty images stock
Order Sekarang
 500×500
500×500
surface contamination detection environmental cleaning masterseries
Order Sekarang
 850×574
850×574
probability surface contamination scientific diagram
Order Sekarang
 1898×609
1898×609
surface contamination monitors bertin technologies
Order Sekarang
 1024×1024
1024×1024
introduction surface contamination aircare international
Order Sekarang
 546×508
546×508
areas mapping surface contamination scientific diagram
Order Sekarang
 768×1024
768×1024
land surface contamination radioactive contamination
Order Sekarang
 626×268
626×268
premium photo water pollution surface contamination
Order Sekarang
 1000×745
1000×745
show science surface contamination global biorisk advisory
Order Sekarang
 850×335
850×335
proposed interaction surface contamination airborne
Order Sekarang
 418×367
418×367
effect surface contamination scientific diagram
Order Sekarang
 850×153
850×153
typical surface contamination characteristics polymer clean
Order Sekarang
 1135×748
1135×748
floor surface contamination controlled environments change
Order Sekarang
 850×1202
850×1202
role surface cleanliness contamination control
Order Sekarang
720×540
720×540
assessing surface contamination dermal hazards powerpoint
Order Sekarang
 198×298
198×298
developments surface contamination cleaning st edition
Order Sekarang
 1033×686
1033×686
contamination xps library xps technology science
Order Sekarang
 1000×1000
1000×1000
surface contamination stats asia pacific pte sg
Order Sekarang
 198×300
198×300
developments surface contamination cleaning vol st
Order Sekarang
Temukan solusi terbaik untuk kenyamanan ruang Anda dengan Surface Contamination! Produk peredam suara dan panas ini menawarkan performa maksimal dengan harga yang terjangkau. Dapatkan kualitas unggul tanpa menguras kantong, dan nikmati suasana tenang serta sejuk di setiap sudut rumah atau kantor Anda. Pilih Surface Contamination – pilihan cerdas untuk investasi jangka panjang!
Maaf, tidak ada yang cocok dengan kriteria yang Anda cari.
Apa yang ingin Anda lakukan?
« kembali ke Beranda atau gunakan kotak pencarian dibawah ini untuk mulai penelusuran baru.









